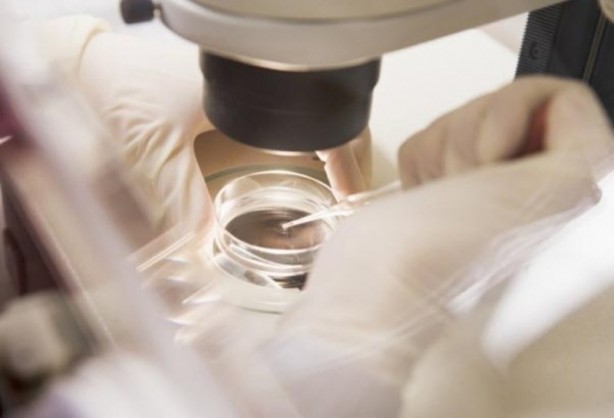
Foto - ABD'li bilim insanları domuz bedeninde insan organı yetiştirilecek
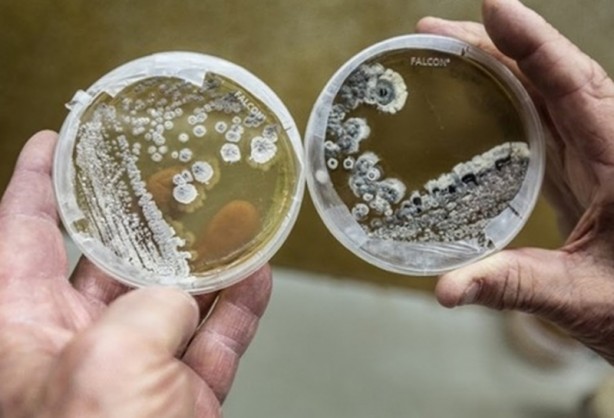
Foto - ABD'li bilim insanları domuz bedeninde insan organı yetiştirilecek

ABD'li bilim insanları domuz bedeninde insan organı yetiştirilecek
Amerika Birleşik Devletleri'ndeki bilim insanları, insanlara nakledilmek üzere domuzlarda insan organları geliştirmeyi deniyor.
Amerika Birleşik Devletleri'ndeki bilim insanları, insanlara nakledilmek üzere domuzlarda insan organları geliştirmeyi deniyor.
Domuz embriyolarına enjekte edilen kök hücreler ile "chimera" olarak bilinen insan-domuz melezi embriyoları geliştirilme çalışmaları başlatıldı.
BBC'de yer alan habere göre bu çalışma, dünya çapında karşılanamayan organ nakli ihtiyacı için bir alternatif bulma arayışının parçası olarak yürütülüyor.
California Davis Üniversitesi'ndeki ekip, geliştirilen domuz embriyolarının, normal domuzlara benzer yapıda ve biçimde olduklarını ancak organlarından birinin insan hücrelerinden oluştuğunu söylüyor.
İnsan kök hücreleri domuzlara naklediliyor.
Chimera embriyolarının geliştirilmesi iki aşamada oluyor.
İlk olarak CRISPR olarak bilinen bir genetik değiştirme yöntemiyle yeni oluşan bir domuz embriyosunun DNA'sı ayrıştırılıyor.
Sonra da embriyoda oluşan boşluğa gen manipülasyonu yöntemiyle "iPS" denilen hücreler yerleştiriliyor.
Yetişkin bir insandan alınan iPS hücreleri manipüle edilerek kök hücreye dönüştürülüyor.
Böylece domuzun vücudunda herhangi bir organa dönüştürülme potansiyeline kavuşuyor.
Bu insan kök hücrelerinin domuz embriyosundaki boşluktan faydalanarak embriyonun insan pankreası oluşturması bekleniyor.
Oluşacak pankreasın insanla genetik olarak aynı özelliklere sahip olacağı vurgulanıyor.
Bu yöntemle organ bağışına ihtiyacın azalabileceği
Ya da vücudun nakledilen organı reddetmesi gibi vakaların engellenebileceği ifade ediliyor.
Halihazırda yeni bir böbrek ya da karaciğer gibi organların nakli için ,
Milyonlarca insanın bağış beklediği tahmin ediliyor.
WhatsApp İhbar Hattı
+90 (553) 313 94 23